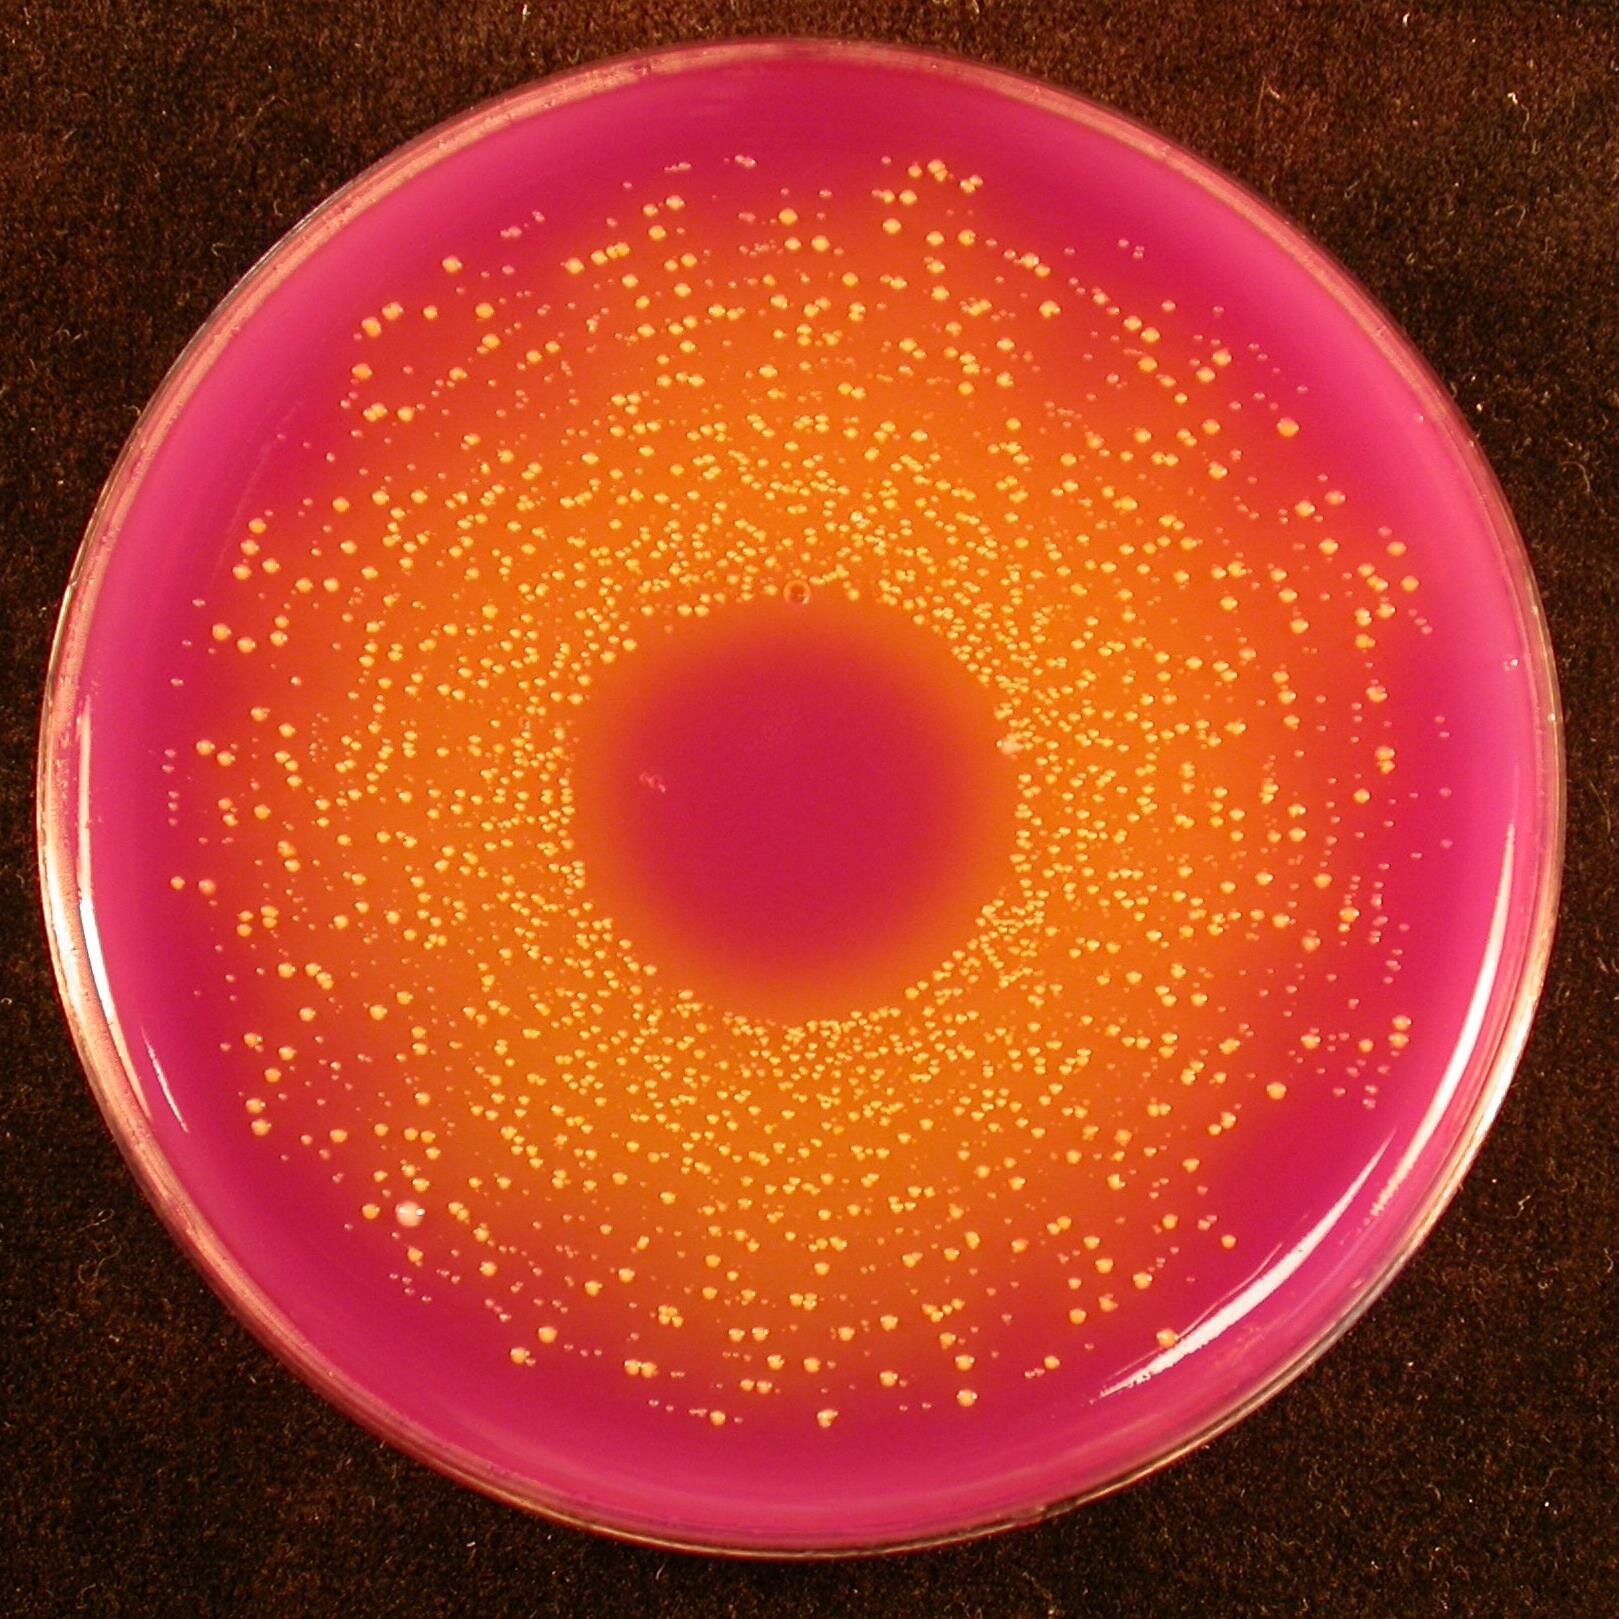

ManMet Life Sciences @MMU_LifeScience
Twitter account for all past, present and future students in the Dept. of Life Sciences @ManMetUni. Tweets from @LCoulthwaite. News, jobs and events. www2.mmu.ac.uk/life-sciences/ Manchester Joined May 2014-
Tweets4K
-
Followers924
-
Following456
-
Likes2K
Congratulations to our Biomedical science Final year immunology team (Lisa Lee-Jones, Lauren McNeil, Nicolas Pionnier, Ria Weston) for being shortlisted for the Award of 'Outstanding Commitment to Inclusive Learning and Teaching' #McrMetProud theunionmmu.org/articles/teach…
If you’re considering postgrad study, come along to our Manchester Metropolitan Postgrad Open Day on Wednesday 1 May, 2– 6pm. We run MSc courses including Biomedical Science, Human Physiology, Medical Microbiology and more. book online at tinyurl.com/ypwzw2fp See you there 😊
Exciting event celebrating and showcasing the fantastic work of final year students at Man Met on 29th May 2024 from 3pm: FESTIVAL OF NEW TALENT - BRIDGES TO NEW WORLDS Find out more and book your place to attend and celebrate the work of your peers at mmu.ac.uk/careers/festiv…
Wishing all our students, staff, alumni and partners a joyous Eid al-Fitr!🧡 #EidMubarak
Wishing all our students, staff, alumni and partners a joyous Eid al-Fitr!🧡 #EidMubarak
Faculty of Science and Engineering Mixed Volleyball Tournament Wednesday 24th April 13:30-16:00 Sugden Sports Centre Rise x Future Me at Manchester Met (mmu.ac.uk)
Join Eviosys team as a Packaging Science Apprentice. 🔬 In this role, you'll assist in pack testing and provide technical support while pursuing a Laboratory Scientist (Chemical Science) Degree Apprenticeship at @ManMetUni. Apply now 👉 ow.ly/1HrG50Rb6v1
Celebrating papers published: Karaganeva R, Tomlinson DJ, Pinner S, Taylor RL, Burden A, & Winwood K (2024) “The effect of custom-made mouthguard design on physiological parameters and players perception in rugby union”. European J. of Sport Science. e-space.mmu.ac.uk/633204/
Looking for a paid summer job or a part-time job next year? 😎 Check out Jobs4Students now - there are currently 153 vacancies available including: Scientific Research (Life Sciences) | recruitment.mmu.ac.uk/vacancies/1023… Apply ASAP! ⏰ Find all vacancies here: recruitment.mmu.ac.uk ☀
The epidemiology of #fungal infections in #transplant patients sciencedirect.com/science/articl… #OpenAccess #fungi #mycology
📰 Director of Apprenticeships, @Lizgorb MBE, shares her thoughts on the future of apprenticeships, and degree apprenticeships at @ManMetUni mmu.ac.uk/news-and-event…
We have three-year fellowships available at MMU and we are a super friendly gang! Neuroscience and Nature-based solutions are just some of the research areas up for grabs 😃
We have three-year fellowships available at MMU and we are a super friendly gang! Neuroscience and Nature-based solutions are just some of the research areas up for grabs 😃
3 year Fellowships available in Musculoskeletal Health at ManchesterMet!! Access 3T MRI and MRS, biopsy and cell biology as well as biomex and physiological testing. Great salary and great environment for world class research. Apply now! manmetjobs.mmu.ac.uk/jobs/vacancy/r…
Collaborative Training event for mentors and verifiers involved in supporting #IBMS RP training
Anatomical Pathology Technician wanted: tinyurl.com/45k63nd4 #jobs #manchester #laboratorymedicine
#Bionow #LifeSciences #Careers Fair 14th March (online) from 9.30am. Opportunities across Biology, Biomedical and Pharmaceutical sectors and beyond. Free to attend for @ManMetUni students. Register for a student delegate pass now at bionow.co.uk/event/BIONOW151
CVRG's Ria Weston thoroughly enjoyed the excellent interaction with some very motivated pupils at this event yesterday @MMUEngage @MMU_LifeScience
CVRG's Ria Weston thoroughly enjoyed the excellent interaction with some very motivated pupils at this event yesterday @MMUEngage @MMU_LifeScience

Manchester Metropolit... @ManMetUni
57K Followers 1K Following Official account of Manchester Metropolitan University.
Dr Natasha Hadgraft @NEHadgraft
377 Followers 823 Following Lecturer in Cardiovascular Biology. Living in Greater Manchester. Passionate about cardiac physiology🔬❤ All opinions are my own
MMU Thrombosis Resear... @MMU_thrombosis
614 Followers 313 Following Thrombosis Research Group at MMU. We are interested in the cellular mechanisms that cause thrombosis.
National School of He... @NSHCS
9K Followers 1K Following We have national responsibility for management of the educational framework for training & development of healthcare scientists across more than 40 specialties.
Sarah Jones @Drsjones1982
630 Followers 565 Following Associate Professor @MMU; Platelet and Endothelial Cell biologist interested in MI, stroke and thrombosis complications in pregnancy.
marilena crescente @marilenacresce1
320 Followers 316 Following Scientist, traveller, tennis player, pizza lover
Robyn Grant @RobynAnneGrant
1K Followers 387 Following Comparative Anatomy, Physiology & Behaviour Scientist. Sensory Biologist. Interested in all things whisker-related! Views are my own.
MANDRAKE @MANDRAKE_LAB
4K Followers 657 Following MANchester DRug Analysis & Knowledge Exchange. Award winning partnership working to deliver effective harm reduction through excellence in science.
Tiago Peçanha @tiagopecanha
2K Followers 2K Following Senior Lecturer in Cardiovascular Physiology at @ManMetUni_SES and @McrInstSport. 🇧🇷🇬🇧. Biscuit sommelier🍪. Caminhante 🥾. Views are my own. YNWA.
IBMS Manchester Branc... @IbmsManc
635 Followers 228 Following Institute of Biomedical Science, Manchester Branch Committee. News and information for members. No endorsements. Any personal views are accidental.
IBMS #AtTheHeartOfHea... @IBMScience
14K Followers 2K Following Institute of Biomedical Science (IBMS) - supporting, progressing and promoting the careers of our members. #BecomeABiomedicalScientist #AtTheHeartOfHealthcare
James Redfern @DrJamesRedfern
2K Followers 2K Following Reader in Microbiology, Dept. Natural Science, Manchester Met, UK. I like all things biofilm, antimicrobials, test methods and much more
Lab Medicine MFT @LabMedicineMFT
2K Followers 337 Following One of the largest NHS laboratories in the UK, delivering pathology services to Manchester and beyond
Happy Histologist @AlixCostello
320 Followers 338 Following HCPC Registered Senior Biomedical Scientist and Clinical Scientist in Histopathology All views are my own🥼👩🔬🔬
Dr Lewis Mattin @MatadorMattin
489 Followers 851 Following Senior Lecturer in Human Physiology @Uniwestminster Research appetite regulation &GI function EX-International Swimmer @thePhySoc @Soc_Endo #OTBC #LGBTQIA🏳️🌈
Prof Cloutman-Green�... @girlymicro
5K Followers 3K Following Lead Healthcare Scientist & IPC Consultant. Passionate about SciCom. Gamer, TV/movie fan, tea drinker & wife of the best guy on the planet - all opinions my own
MMU Library @MMULibrary
6K Followers 1K Following For news and updates follow us on: 📸 IG: MMULibrary 👍FB: MMULibraryServices 🖥️ YouTube: MMULibraryServices
Rob Shorten @robshorten
2K Followers 5K Following Consultant Clinical Scientist in microbiology (& rubbish drummer) with a love for music, ale & dry roasted peanuts. Opinions are my own. He/him 🏳️🌈🏳️⚧️
Adam Hawker @AdamHawker6
373 Followers 605 Following Clinical Scientist 👨🏻🔬Ready to explore the world ✈️ |views are my own| 🏳️🌈
Manchester Met Instit... @McrInstSport
2K Followers 518 Following Pushing boundaries, improving lives and shaping society at Manchester Metropolitan University. Home to the Centre of Excellence for Women in Sport.
Ruthie K @ruthie_kerr
127 Followers 1K Following Fluent in 3 languages - English, sarcasm and profanity
ronan o'cualain @ronanocualain
450 Followers 1K Following Likes: footy, cycling, and well-behaved mass spectrometers. Dislikes: Dirty samples
Experimental Physiolo... @ExpPhysiol
14K Followers 2K Following Experimental Physiology publishes original research exploring homeostatic and adaptive responses in health and pathophysiological mechanisms in disease
Ana Cauchi @AnaCauchi
3 Followers 24 Following Sport and Exercise Science student at the University of Bath.
ABDULKARIM MBARAKA @ABDULKARIMMBA10
17 Followers 320 Following
Hafeez Rehman @MrHRehman
126 Followers 644 Following Apprentice Healthcare Scientist, Biology BSc, Houseplant Enthusiast 🪴
David @WeipingLin_2021
0 Followers 5 Following
John-Joe Reilly @jayjayaah
655 Followers 1K Following Consultant in Major Trauma and Emergency Surgery, Head of Emergency Surgery, Nottingham University Hospitals. @EastMidsMTC @nottmhospitals.
Alejandra Tomás Cata... @TomasLab_ICL
2K Followers 7K Following Professor & Head of Section of Cell Biology and Functional Genomics @imperialcollege. Spatiotemporal regulation of signalling of metabolically relevant GPCRs.
Luke McIlvenna @LukeMcIlvenna
1K Followers 3K Following Scientist | Extracellular Vesicles | Senescence | Physiology | Cell Biology | Exercise Metabolism
Jonathan Butler @Campylobutler
40 Followers 69 Following Senior Lecturer. Researcher in AMR, novel antimicrobials and foodborne infections.
Life Science Events @lsn_events
6K Followers 6K Following Events in life sciences. Join https://t.co/wcjnMrUBqK to get notified about science conferences and seminars in your area.
Mosunmola @arin_wudd
2K Followers 2K Following Live everyday like it’s your last day on earth 😚 and have fun
Llyssa @Llyssia1
14 Followers 303 Following
Process Record Slide @IHC_PRS
844 Followers 5K Following The first #immunohistochemistry (IHC) device to add QC monitoring for the patient tissue section on a single glass slide in accordance with @WHO requirement
Helena A @HelenaAstbury
415 Followers 2K Following
king @kingprimeo
36 Followers 600 Following Bsc. biological science Education ||teacher|| football enthusiast || Man United
Trevor Stott-Briggs @TrevorStottB
32 Followers 66 Following Its a satirical, political, parody about the Trumper and BoJo in the style of 'Alice in Wonderland meets 'Private Eye' & 'Spitting Image'. Check on https://t.co/4rwjfd0Csv
Em Frads 🏳️�... @emfradss
49 Followers 2K Following 26 he/she/they - starting training as a clinical scientist in blood science - lover of the weird, wonderful and useless ❤️
The Pathologist @pathologistmag
18K Followers 2K Following Reporting on the research, innovations, personalities, and policies that shape #pathology 🔬 Editor: @patholo_brist Deputy: @JessicaATexere
Dan Johnson @danmjohnson
1K Followers 1K Following Researcher in cardiac (electro)physiology Lecturer @OpenUniversity #Springboard @acmedsci Chair @ESCardio WGCCE #SoMe @JMCCPlus Dad All tweets my own
MST Drama & Contempor... @mstdcp
364 Followers 894 Following We are the BA Drama & Contemporary Performance course at Manchester School of Theatre @ Manchester Metropolitan University @mcrschart @manmetuni @mcrschart_prg.
Mariam @mayfuns001
77 Followers 400 Following The goal is to get better everyday... Take up new challenges... Still doesn't know the me yet but don't get it twisted, I'm#GBE challenge... It's now
Art Research Group @McrSchArt_ARG
398 Followers 1K Following The Art Research Group @mcrschart @manmetuni @mmu_research focuses on practice-based and theoretical research in Curating, Fine Art and Visual Culture.
Life Science Network @lifesciencenet
21K Followers 19K Following A platform for life sciences. Publications, research protocols, news, events, jobs and more. Sign up at https://t.co/xfb4I8iNYS.
Prof Michelle McManus @McManus_M_
3K Followers 3K Following Co-Director of the Institute for Children’s Futures (ICF), Professor of Safeguarding & Violence Prevention @ManMetUni Tweets are my own
NandhiniSuriya @NandhiniSuriya_
3 Followers 35 Following Nandhini Suriya Narayanan👑💫 Microbiologist💉
The Unitarian Skeptic @MonotheistC
571 Followers 3K Following Ex-Trinitarian, Ex-Atheist, Monotheist, Critical Thinker, Pro-Life, Evidentialist, History, Archaeology, Doctrine, Theology, Philosophy, Apologetics & Religion
Careers at Northern C... @NCACareersNHS
5K Followers 2K Following The place where jobs are posted and career opportunities are promoted! This is the NHS Recruitment account for the Northern Care Alliance. Messages welcome!
Thalia Holdom @THoldom
13 Followers 70 Following
Ferdinandbms🇳🇬�... @AgbalikoF
94 Followers 369 Following A Medical Laboratory Scientist A Biomedical Scientist A Fish Farmer A Business Man
Claire Walker @walkerclairegm1
263 Followers 1K Following 'Partnership & Quality Lead' supporting & developing future talent for a thriving & prosperous GM economy @YourGMACS @GMWorkandSkills
Ami Sultan @sultan_amy
40 Followers 80 Following Woman in Stem documenting her random thoughts 🧪🔬 ٱلْحَمْدُ لِلَّٰهِ
Candle Of the Life �... @Candle_of_Life
315 Followers 2K Following أحيوا الحق بذكره وأميتوا الباطل بتركه...عمر ابن الخطاب رضي الله عنه. إن كان شوقي هوى فشوقي كله مكة♥️. 🇺🇸🇸🇦🇳🇱🗣
Anna Aitken @AnnaAitken_
339 Followers 1K Following MRes student researching peatland hydrology at woodland edges at Forest Research and University of Leeds. Former @MMUBioRecs and @OU_EEE
Saaemah Chhadat @saaemahc
15 Followers 19 Following
Sonya Raja @sonya_raja3
0 Followers 88 Following
Eric Lou @EricLouMCR
403 Followers 538 Following Faculty Head of International | Reader | Project Management | Manchester Metropolitan University | Footie | Foody | Daddy | own views here
Alexander Brill @AlexanderBrill8
170 Followers 92 Following Associate Professor, Senior British Heart Foundation Research Fellow, University of Birmingham
Greater Manchester Di... @GM_Diagnostics
305 Followers 219 Following A collaborative pathology network across the seven GM NHS provider organisations which will strive to deliver better patient care.
Manchester Metropolit... @ManMetUni
57K Followers 1K Following Official account of Manchester Metropolitan University.
MMU Thrombosis Resear... @MMU_thrombosis
614 Followers 313 Following Thrombosis Research Group at MMU. We are interested in the cellular mechanisms that cause thrombosis.
National School of He... @NSHCS
9K Followers 1K Following We have national responsibility for management of the educational framework for training & development of healthcare scientists across more than 40 specialties.
Sarah Jones @Drsjones1982
630 Followers 565 Following Associate Professor @MMU; Platelet and Endothelial Cell biologist interested in MI, stroke and thrombosis complications in pregnancy.
Professor Dame Sue Hi... @CSOSue
11K Followers 7K Following I am the Chief Scientific Officer for England and the Senior Responsible Officer for Genomics in the NHS
marilena crescente @marilenacresce1
320 Followers 316 Following Scientist, traveller, tennis player, pizza lover
Robyn Grant @RobynAnneGrant
1K Followers 387 Following Comparative Anatomy, Physiology & Behaviour Scientist. Sensory Biologist. Interested in all things whisker-related! Views are my own.
IBMS Manchester Branc... @IbmsManc
635 Followers 228 Following Institute of Biomedical Science, Manchester Branch Committee. News and information for members. No endorsements. Any personal views are accidental.
RC of Pathologists @RCPath
14K Followers 752 Following The Royal College of Pathologists promotes excellence in the practice of pathology. Members work across 17 specialties in healthcare, universities & industry.
IBMS #AtTheHeartOfHea... @IBMScience
14K Followers 2K Following Institute of Biomedical Science (IBMS) - supporting, progressing and promoting the careers of our members. #BecomeABiomedicalScientist #AtTheHeartOfHealthcare
James Redfern @DrJamesRedfern
2K Followers 2K Following Reader in Microbiology, Dept. Natural Science, Manchester Met, UK. I like all things biofilm, antimicrobials, test methods and much more
Lab Medicine MFT @LabMedicineMFT
2K Followers 337 Following One of the largest NHS laboratories in the UK, delivering pathology services to Manchester and beyond
NHS England @NHSEngland
515K Followers 2K Following We lead the NHS in England to deliver high quality services for all.
Microbiology Society @MicrobioSoc
76K Followers 2K Following Microbiology Society: A world in which the science of #microbiology provides maximum benefit to society | https://t.co/tMDafCE6df
Dr Lewis Mattin @MatadorMattin
489 Followers 851 Following Senior Lecturer in Human Physiology @Uniwestminster Research appetite regulation &GI function EX-International Swimmer @thePhySoc @Soc_Endo #OTBC #LGBTQIA🏳️🌈
Rehan Junejo @RTJunejo
280 Followers 588 Following Academic @ManMetUni | Research: Cerebro- & Cardiovascular control in health & disease | Research Fellow @LiverpoolCCS
Prof Cloutman-Green�... @girlymicro
5K Followers 3K Following Lead Healthcare Scientist & IPC Consultant. Passionate about SciCom. Gamer, TV/movie fan, tea drinker & wife of the best guy on the planet - all opinions my own
MMU Library @MMULibrary
6K Followers 1K Following For news and updates follow us on: 📸 IG: MMULibrary 👍FB: MMULibraryServices 🖥️ YouTube: MMULibraryServices
Rob Shorten @robshorten
2K Followers 5K Following Consultant Clinical Scientist in microbiology (& rubbish drummer) with a love for music, ale & dry roasted peanuts. Opinions are my own. He/him 🏳️🌈🏳️⚧️
Adam Hawker @AdamHawker6
373 Followers 605 Following Clinical Scientist 👨🏻🔬Ready to explore the world ✈️ |views are my own| 🏳️🌈
Manchester Met Instit... @McrInstSport
2K Followers 518 Following Pushing boundaries, improving lives and shaping society at Manchester Metropolitan University. Home to the Centre of Excellence for Women in Sport.
Neuroscience_MMU @NeuroscienceMmu
137 Followers 186 Following MMU neuroscience group Neuroinflammation; Dementia & Age-related Neuropathologies; Developmental Programming & Molecular Aging and Neurophysiology Views our own
Eima Karim @EimaKarim6
112 Followers 182 Following PhD researcher in Cardiovascular Science https://t.co/GkKYhOIXDM
Ginny Hawkins @GinnyHawkins4
137 Followers 136 Following Neurophysiology, glial cells, neurovascular coupling and controlling our breathing
Chris van der Gast @ChrisvanderGast
405 Followers 317 Following Professor of Microbiome Ecology. Gut & Lung Microbiomes in Cystic Fibrosis. #Firstgen
gordon mcnair @gormcn
68 Followers 99 Following
Professor Alun Willia... @RugbyGeneStudy
1K Followers 859 Following RugbyGene examines the genetics of health & performance in elite rugby. Views mine not my affiliations' @McrInstSport @ManMetUni_SES @TheISEH @SUSciEng
MMU Nutritional and E... @NutrExPhysMMU
164 Followers 99 Following Nutritional and Exercise Physiology research team @ManMetUni @MMU_CBS. Lead principle investigators @GethinHEvans and @adorayau.
MMU Centre for Biosci... @MMU_CBS
180 Followers 112 Following MMU Centre for Bioscience: Delivering innovative research to elevate understanding and inform treatment of the UK's most prevalent diseases.
Diane Ashiru, PhD @DrDianeAshiru
9K Followers 4K Following Lead Pharmacist HCAI & AMR. Hon Chair & Prof of Pharmaceutical Public Health. Chair #ESPAUR, #Antibioticguardian. Mum. #FRPharmS (consultant). #TEDx x2 Views mi
MFT_Pharmacy @MFT_Pharmacy
1K Followers 1K Following Welcome to Manchester University NHS Foundation Trust Pharmacy twitter page
Perfectus Biomed Grou... @perfectusbiomed
492 Followers 448 Following Perfectus Biomed are an award-winning Contract Research Organisation.
MMU Dept. SESs @ManMetUni_SES
599 Followers 354 Following Department of Sport and Exercise Sciences at Manchester Metropolitan University. #ManMetUni
LiCa Scientific Rec @licasci
168 Followers 671 Following We match scientists with their next career opportunity
Prof Helen Laville @HelenLaville1
394 Followers 132 Following Provost, Kingston University. All views here are my own.
NHS Graduate Manageme... @NHSGradScheme
18K Followers 2K Following A fast track to a non-clinical senior leadership career. Post-grad quals, regional placements, support network and more. Applications now closed for 2024 entry.
Mike Dempsey @MikeDempseyMMU
22 Followers 4 Following
Jo Martin 💙 @JoMartin_path
4K Followers 1K Following Professor of Pathology, Deputy Vice Principal Health @QMUL. Past President @RCPath @NHSBartsHealth hon consultant. GI neuropathology ++ (she/her)
Action on Antibiotic ... @ActionDrug
397 Followers 77 Following Student led organisation aiming to promote a safer use of antibiotics. Free course on antibiotics:https://t.co/uB7ni5mjQf
Quadram Institute @TheQuadram
11K Followers 3K Following At the forefront of research into food, the gut microbiome, and human health. Partnership between Quadram Institute Bioscience, @NNUH, @uniofeastanglia & @BBSRC
MMU Society for Healt... @MMUHealthSciSoc
12 Followers 0 Following New Society for 2018-19 at MMU. If you're interested in Healthcare Science, please join!
Rachel Cleaton @Rachchatter
658 Followers 927 Following Pathology Practice Educaton Co-ordinator, South Midlands Pathology Network(ME4),HCPC-registered Biomedical Scientist,Kids Church Leader, own views
Liz Gorb MBE @Lizgorb
819 Followers 1K Following Degree Apprenticeships, enterprise, education, music, Strategic Advisor at Manchester Metropolitan University, my views are my own
Advance HE @AdvanceHE
23K Followers 854 Following We are a charity dedicated to helping higher education transform lives by realising the potential of its people.
PrintCity: 3D, Innova... @PrintCityMMU
1K Followers 458 Following Digital centre in the North West focusing on additive manufacturing. Printing the future. Print anything.
Dr Jo Horne @hornej13
5K Followers 5K Following STP Training Programme Director @NSHCS; Coach; Assessment; Dysgu Cymraeg
McLaughlinGroup @MML_ResearchQUB
733 Followers 460 Following Senior Lecturer in Organic Chemistry at QUB. My group invent new reactions and use them to make useful molecules. Views my/our own.
Student Journey Trans... @ManMetSJTP
241 Followers 269 Following We're on a mission to transform the student journey at Manchester Met Uni. Join our community to keep up to date with the latest news and events from the SJTP.
Louise Sweeney🦄 @sweeney_louise
507 Followers 641 Following Consultant microbiologist, Manchester, Twin sister, auntie, book lover, fringe fan, Antibiotic Angel. Views are my own.
Phillipa Jane Burns @PhillipaBurns
2K Followers 3K Following On the HSST treadmill, just the DClinSci to conquer! supportive of all infection trainees - DMs always open. slowly moving to bluesky
Tony @scimone_t
143 Followers 620 Following Level 8 Wizard. Secret cycling convert. Drummer and snowboarder. Tweets solely in a personal capacity and almost certainly about the metrolink.
Rebecca Anderson @becky_ando
64 Followers 395 Following
Lucy Smyth @ljcsmyth
324 Followers 430 Following #Biomedical science #SFHEA #ProgrammeLead #Apprenticedegree #salfordUni. Passionate about clinical research #IBMS careers, gardening & fur-babies. My views.
Stephen McDonald @ChemistryBMS
336 Followers 433 Following Advanced Biomedical Scientist Team Leader, Biochemistry and Pathology Quality Manager
selton smith @SeltonSmith
10 Followers 134 Following
Kirstin Burke @KirstinBurke1
452 Followers 1K Following Careers Advisor supporting Manchester Met University, Faculty of Science & Engineering students/grads make the most of university through meaningful experiences
Emma B @teamjbesr
48 Followers 311 Following
Barry Hill @BarryHill16
28 Followers 70 Following Ex-Blood Bank Manager, laboratory scribe and puppeteer, now enjoying life working in semi-retirement
University Dental Hos... @MDentalHospital
2K Followers 144 Following We are proud to lead in patient safety while treating over 90,000 patients a year. #UDHM
Zonya @zonyajeffrey
195 Followers 200 Following Biomedical Scientist, Training manager & Co-founder of Child Aid Tanzania